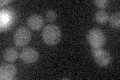
YPR194C
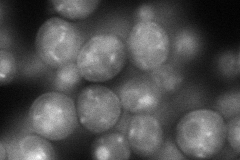
YPR194C
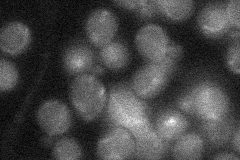
YPR194C
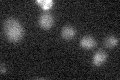
YPR194C

View description
Oligopeptide transporter; member of the OPT family, with potential orthologs in S. pombe and C. albicans; also plays a role in formation of mature vacuoles
Localization:
Intensity:
Fold change:
Significance:
-
C’ GFP library in SD
below threshold13.49 -
N' NOP1pr-GFP in SD
punctate,vacuole108.004 -
N' TEF2pr-mCherry in SD

vacuole102.706 -
N' NATIVEpr-GFP in SD
below threshold20.9777 -
N' TEF2pr-VC and Cyto-VN in SD

below threshold28.4666 -
C’ GFP library in SD+DTT

cytosol14.621.08No -
C’ GFP library in SD+H2O2

cytosol15.321.13No -
C’ GFP library in Starvation Media
cytosol17.041.26No -
C’ GFP library on the background of Pup2-DaMP

N/A -
C’ GFP library on the background of CCT mutant

N/A0N/AYes
